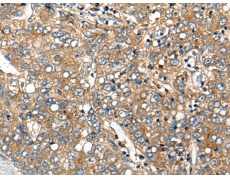
一抗

中文名稱:兔抗CDHR4多克隆抗體
別 名: cadherin related family member 4; CDH29; PRO34300
儲(chǔ) 存: 冷凍(-20℃)
宿 主: Rabbit
反應(yīng)種屬: Human
標(biāo) 記 物: Unconjugate
克隆類(lèi)型: rabbit polyclonal
技術(shù)規(guī)格
|
Background: |
Cadherins are calcium-dependent cell adhesion proteins. They preferentially interact with themselves in a homophilic manner in connecting cells; cadherins may thus contribute to the sorting of heterogeneous cell types (By similarity). |
|
Applications: |
ELISA, IHC |
|
Name of antibody: |
CDHR4 |
|
Immunogen: |
Synthetic peptide of human CDHR4 |
|
Full name: |
cadherin related family member 4 |
|
Synonyms: |
CDH29; PRO34300 |
|
SwissProt: |
A6H8M9 |
|
ELISA Recommended dilution: |
5000-10000 |
|
IHC positive control: |
Human liver cancer |
|
IHC Recommend dilution: |
25-100 |

 購(gòu)物車(chē)
購(gòu)物車(chē) 幫助
幫助
 021-54845833/15800441009
021-54845833/15800441009